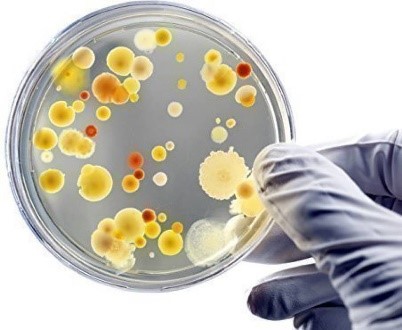

Túnel de descontaminação recebe laudo do Instituto de Biologia da Unicamp
O túnel de descontaminação teve laudo com teste de eficácia no combate a vírus emitido pelo Laboratório de virologia do Instituto de Biologia da Universidade

O túnel de descontaminação teve laudo com teste de eficácia no combate a vírus emitido pelo Laboratório de virologia do Instituto de Biologia da Universidade
De acordo com a OMS, mais de 50% dos locais fechados têm ar de má qualidade, o que se deve principalmente à má higienização dos

A atual pandemia de coronavírus (Covid-19) é causada pelo vírus SARS-CoV-2, um coronavírus encapsulado, composto por uma única cadeia de RNA, que é transmitida principalmente

A indústria alimentícia é um dos setores que mais cresce no mundo inteiro. Em nosso país, segundo um levantamento da ABIA – Associação Brasileira da Indústria de
Está preparado para mais uma grande experiência? Então reserve sua agenda! Dia 17 de março em São Paulo, você terá a oportunidade de participar do

No dia 12 de fevereiro, em São Paulo, GMP+ International e Markovic Food Management trarão palestras e apresentações sobre o universo feed, além de painéis

Quais serão as principais mudanças que teremos na legislação? Como lidar com a enxurrada de desinformação que circunda a área de alimentos? O que o
Este é o resumo da palestra ministrada no II Food Safety Brazil Meeting.

O IRSFD, entidade sem fins lucrativos, convida você para juntos sonharmos alto: “Que tal promovermos e disseminarmos a ideia Global Markets da GFSI por todo

Atuo há 13 anos no mercado de segurança dos alimentos, acompanhando validações de sistemas de higiene e treinando times de indústrias de diversos segmentos, no

Os geradores de ozônio estão se tornando mais acessíveis e são uma característica comum em grandes áreas comerciais. O uso doméstico, medicinal e industrial de

A quinta edição Latino Americana do Sustainable Foods Summit acontecerá em São Paulo nos dias 28 e 29 de novembro de 2019 e apresentará questões

Não é raro que, ao ter que notificar um colega, ou um cliente, ou um fornecedor de que, depois de uma análise de laboratório, o

A prevalência de alergias alimentares cresce ao longo dos anos, mobilizando a saúde pública global e localmente, num cenário onde evitar consumir o alimento potencialmente

Há muitos fatores que demandam atenção da indústria alimentícia para que o produto chegue impecável à mesa dos consumidores, entre eles, a escolha dos fornecedores

Sempre antenada com os assuntos de maior relevância para a proteção dos alimentos, a Abrapa está oferecendo o XV Simpósio Internacional centrado no tema Fraude

Reduza os testes periódicos da sua linha de produção e transforme tempo em dinheiro Testar um detector de metais manualmente pode ser desafiador devido ao

Você sabia que está prevista para maio de 2019 a publicação da FSSC 22000 na versão 5.0? Esta atualização bastante profunda incorporará a ISO 22000:2018 e novos

Evento acontece dia 3 de abril em São Paulo e traz palestras das principais autoridades do segmento de segurança dos alimentos São Paulo, fevereiro de

Como será o ano de 2019 para o mercado de alimentos? Quais serão as principais mudanças que teremos na legislação internacional? Como as normas de

Desde 2006 a 3M promove o Programa Cultivando Talentos, que patrocina e premia os melhores projetos com foco em microbiologia de alimentos. Nosso objetivo é fomentar a

Você já se perguntou se os lubrificantes que você está usando em sua comida ou instalação de produção são seguros? Este artigo irá ajudá-lo a

O tema Utilidades Limpas é de importância na indústria farmacêutica e alimentícia. O I Fórum de utilidades limpas contemplará temas como: HVAC: controle do ar ambiente

Recentemente foram publicadas algumas matérias polêmicas sobre a nova tendência nos Estados Unidos de consumo de água engarrafada “sem tratamento” – chamada também de “água